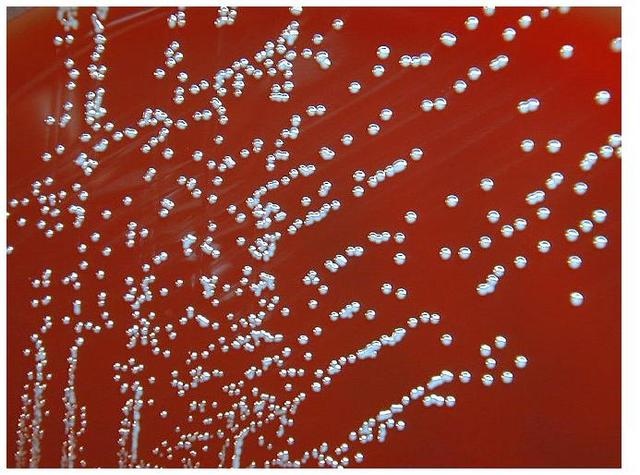
Estirpes De Brucela

-
En 1902, Maurice Nicolle (1862-
1932) y Mustafa Adil-Bey (1871-1904) demostraron
que el agente causal de esta enfermedad también era
un virus; fue una verdadera sorpresa, ya que la peste
humana era de origen bacteriano, como lo habían
demostrado Alexandre Yersin (1863-1943) y Shihasaburo Kitasato (1852-1931). La peste bovina fue
eliminada progresivamente de Europa mediante medidas de profilaxis higiénica. -
En 1907, se fundo la Escuela Libre De Medicina Veterinaria De la Habana, Actualmente Facultad De Medicina Veterinaria
-
Uno de los hechos más importantes de la veterinaria en el siglo XX fue la incorporación de la mujer a
la profesión. Como ocurrió con otros ámbitos de la
sociedad, se produjo muy lentamente, con serias polémicas y con el rechazo frontal de amplios sectores
masculinos, que no podían soportar la visión de una
mujer tratando a vacas, cerdos o caballos (9).
Las revistas especializadas españolas se hicieron eco
a partir de 1915 de las primeras mujeres veterinarias. http://tienda.portalveterinari -
Por ejemplo, se publicó el nombramiento de la alemana Marianne Plehn como profesora de la escuela
de Múnich y, en septiembre de 1916, que Eleanor
McGrath se convertía en la primera mujer en ser
admitida como miembro de la American Veterinary
Medical Association. -
Al ocuparnos de los trabajos de
CAYETANO LÓPEZ sobre la vacunación contra la brucelosis bovina,
hemos de destacar en primer lugar
como aportación básica, su excelente medio de cultivo para la Br. Abortus , el agar-placenta glicerinado,que
le permitió mantener vivas durante
varios meses dichas bacterias, con lo
que, según el propio autor, inició sus
primeros estudios, a partir de una
cepa remitida desde Inglaterra por
Mc FADYEAN, hecho que ocurría en
1919. Desde dicha fecha, nuestro
bacteriólogo -
Tras 12 años
largos de experiencias, el 24 de junio
de 1921 deciden aplicar la vacuna a
un niño hijo de madre tuberculosa
recién fallecida que tenía que criarse
y convivir con una abuela también
infectada. -
En 1965, la Organización Mundial de la Salud (OMS) definió el
término zoonosis como “todas las enfermedades e
infecciones en las que pueda existir relación animalhombre y viceversa, bien directamente o a través del
medio ambiente, incluidos portadores reservorios y
vectores”. -
En 1975 comienza un incremento discreto de mujeres licenciadas en Veterinaria.
-
Bernard Bang, veterinario danes, en la decada de los 80 del siglo XIX , descubrio la tuberculina y la leucosis viral de pollos
-
En Enero del 2000 el Doctor Schatten y su equipo obtuvieron en el Centro de Investigación de Primates de Oregón (EEUU) el primer mono clónico. Se obtuvo mediante manipulación de embriones que estaban en fase de 8 células. Las células embrionarias se separaron y sus núcleos se inyectaron en óvulos enucleizados. Estos óvulos se implantaron en el útero de una madre de alquiler. Sólo uno de ellos llegó a término. Dominko, una de los investigadores, hace público en Diciembre de 2001 que un alto porce
-
Una píldora mensual anti-pulgas: Con una píldora al mes, las mascotas podrán estar libres de pulgas y garrapatas. La pastilla, desarrollada por científicos de Nueva Jersey, podría ser 100% eficaz y sin señales de efectos tóxicos para los animales.
Con una píldora al mes, las mascotas podrán estar libres de pulgas y garrapatas. La pastilla, desarrollada por científicos de Nueva Jersey, podría ser 100% eficaz y sin señales de efectos tóxicos para los animales.
A list shows items. A timeline shows sequence.
Use Timetoast to make dates, milestones, and turning points easier to understand in a clear visual format. Timetoast is a timeline maker for work, school, research, and stories.